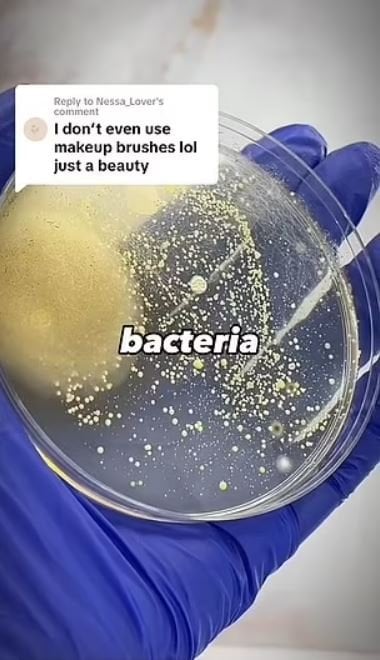

ABD merkezli uzmanlar, bakterilerin ciltteki gözeneklere girmesiyle enfeksiyonların tetiklendiği uyarısında bulunarak, pek çok kirli fırçanın "klozet kapaklarından daha kirli" olduğunu ekledi.

Uzmanlar, kir birikmesini önlemek için insanlara makyaj fırçalarını ve süngerlerini her yedi ila on günde bir yıkamalarını söylüyor.
Ancak veriler Amerikalıların yüzde 22'sinin temizlik yapmadığını, yüzde 39'unun ise bunu ayda birden az yaptığını gösteriyor.
İKİ MİLYONDAN FAZLA İZLENDİ
ABD merkezli makyaj temizleme markası GlamTech'in sosyal medyaya yüklediği bir video, temizlenmemiş fırçaların durumunu gözler önüne seriyor.
İyi kullanılmış, temiz görünen bir sünger ve fırça bir petri kabında siliniyor ve daha sonra inkübasyona kaldırılıyor. Ancak araştırmacılar geri döndüklerinde her yerde bakteri kolonileri oluştuğunu keşfettiklerinde şoka giriyorlar.
Araştırmacılar fırçaların ve karıştırıcıların tuvaletlerden daha kirli olabileceğini söylerken insanlarda çeşitli rahatsızlıklar olmasının sebebinin de bu olduğunu söylediler.
İnternette viral hale gelen gönderi, iki milyondan fazla izlendi ve 150 binden fazla beğeni aldı.